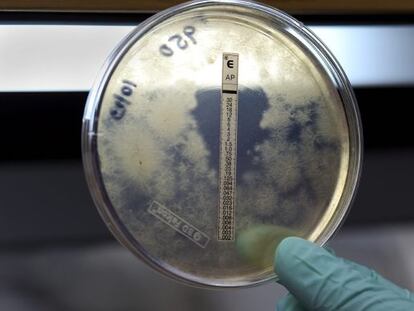

Catarsis en caso de despido: tuitear el descontento
Criticar al jefe en las redes sociales puede servir de desahogo
Criticar al jefe en las redes sociales puede servir de desahogo




"Yo pretendo gobernar para todos, populares, socialistas y nacionalistas. Yo no me presento contra nadie ni pensando en depender de un pacto" asegura el presidente

La Xunta envía cartas a usuarios sin avisar a los municipios
El fotógrafo de Reuters Marcelo del Pozo retrata a afectados por los recortes en La Línea de la Concepción, Cádiz

Bushwick, Fort Greene y Greenpoint. Tres barrios artísticos y multirraciales más allá de Manhattan


Aló, Comidista ¿Por qué lado del papel de aluminio se debe envolver la comida?

Merkel intenta desandar el camino tras el acuerdo del pasado junio sobre la recapitalización bancaria

El fiscal pedía cautelares pero Vidal ha alegado que participará en un 'reality' y estará localizable El concejal socialista queda libre sin fianza pero imputado por cohecho y malversación El juez ha encarcelado a 36 detenidos en la operación Emperador

Hoy, con el Celta y a punto de cumplir 59 años, el técnico catalán se sentará por primera vez en el banquillo del estadio Santiago Bernabéu




Alemania insiste en retrasar la ayuda, redobla la presión para estrechar el control sobre la disciplina fiscal e impone una desnaturalización de la unión bancaria



Muere un manifestante por un paro cardiaco durante la huelga general


Viñeta de Erlich del 19 de octubre de 2012
Las autoridades sanitarias confirman la contaminación De momento hay 20 muertos y 257 infectados en 16 de los 50 Estados de la nación


Ferrero y Ferrer reflexionan en un encuentro organizado por EL PAÍS y la Universitat sobre la derrota en la vida de los tenistas